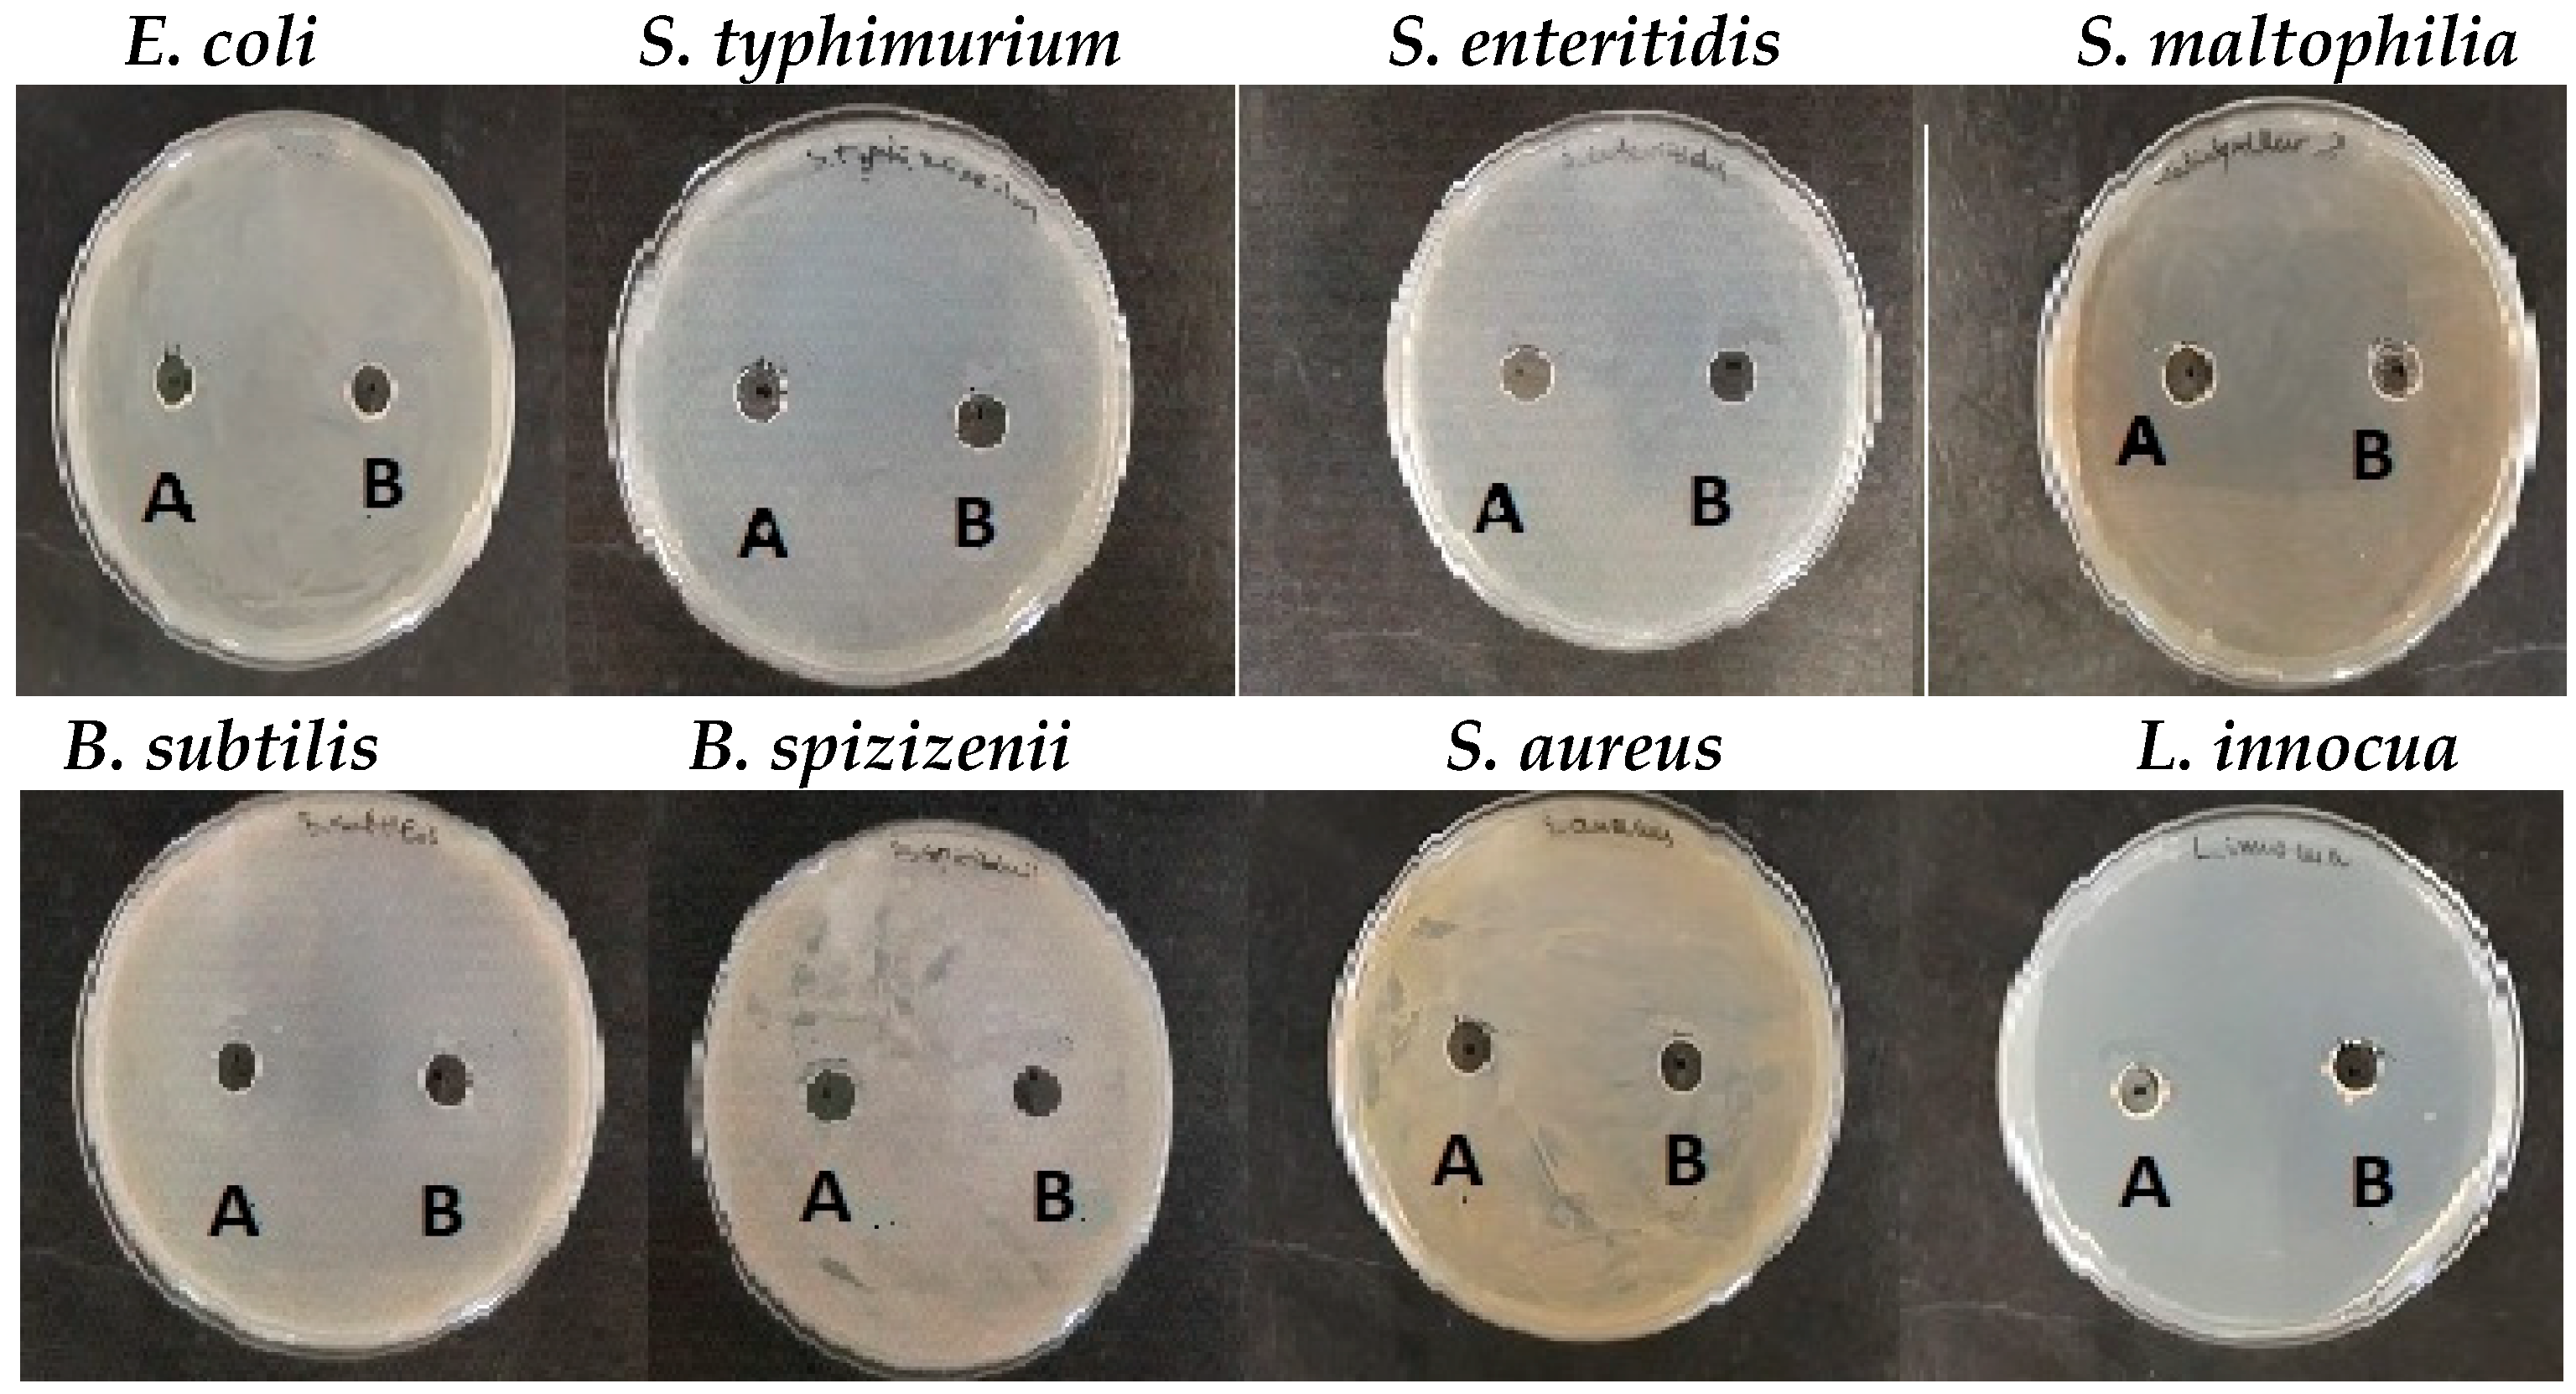
Pharmaceuticals 17 00506 g012

Development of CuO Nanoparticles from the Mucus of Garden Snail Cornu aspersum as New Antimicrobial Agents
Abstract
1. Introduction
2. Results
2.1. Isolation and Characterization of Mucus Extract from Garden Snail C. aspersum
2.1.1. Isolation of Mucus Extract from Garden Snail C. aspersum
2.1.2. Characterization of Mucus Extracts from Garden Snail C. aspersum
2.2. Green Synthesis and Characterization of CuONPs-Muc Using Snail Mucus Extract
2.2.1. Green Synthesis of CuONPs-Muc Using Snail Mucus Extract with MW > 20 kDa
2.2.2. Characterization of CuONPs-Muc Using UV–Vis and Fluorescence Spectroscopy
2.2.3. Characterization of the Obtained CuONPs-Muc by Scanning Electron Microscopy Combined with Energy-Dispersive Spectroscopy (SEM/EDS)
2.2.4. Characterization of CuONPs-Muc Using Raman Spectroscopy and Imaging
2.2.5. Characterization of CuONPs-Muc Using IR Spectroscopy
2.3. Characterization of CuONP-Muc Stability Using TG/DSC-MS Analysis
2.4. Identification of Proteins Involved in Green Synthesis of CuONPs
2.4.1. 1D-PAGE and RP-HPLC Analyses
2.4.2. Image Analysis of 10% SDS-PAGE Using ImageQuant™ TL v8.2.0 Software
2.5. Antibacterial Activity of CuONPs
3. Discussion
4. Materials and Methods
4.1. Sample Preparation
4.2. 1D Polyacrylamide Gel Electrophoresis (1D-PAGE)
4.3. MALDI-MS Analysis of Proteins
4.4. The Synthesis of CuONPs-Muc
4.5. Characterization of CuONPs-Muc Using Ultraviolet–Visible Spectroscopy Analysis
4.6. Characterization of CuONPs-Muc Using Fluorescence Spectroscopy
4.7. Characterization of CuONPs-Muc Using Raman Spectroscopy and Imaging
4.8. Characterization of CuONPs-Muc Using FTIR and TG-DSC
4.9. Image Analysis of 10% SDS-PAGE by ImageQuant™ TL v8.2.0 Software
4.10. RP-HPLC Analysis of CuONPs-Muc
4.11. Antibacterial Activity of CuONPs
5. Conclusions
Author Contributions
Funding
Institutional Review Board Statement
Informed Consent Statement
Data Availability Statement
Acknowledgments
Conflicts of Interest
References
- Kumar, B.; Jalodia, K.; Kumar, P.; Gautam, H. Recent advances in nanoparticle-mediated drug delivery. J. Drug Deliv. Sci. Technol. 2017, 41, 260–268. [Google Scholar] [CrossRef]
- Britto-Hurtado, R.; Cortez-Valadez, M. Chapter 4—Green synthesis approaches for metallic and carbon nanostructures. In Green Functionalized Nanomaterials for Environmental Applications; A volume in Micro and Nano Technologies; Shanker, U., Hussain, C.M., Rani, M., Eds.; Elsevier: Amsterdam, The Netherlands, 2022; pp. 83–127. [Google Scholar]
- Hoag, G.E.; Collins, J.B.; Holcomb, J.L.; Hoag, J.R.; Nadagouda, M.N.; Varma, R.S. Degradation of bromothymol blue by ‘greener’ nano-scale zero-valent iron synthesized using tea polyphenols. J. Mater. Chem. 2009, 19, 8671–8677. [Google Scholar] [CrossRef]
- Horwat, D.; Zakharov, D.; Endrino, J.; Soldera, F.; Anders, A.; Migot, S.; Karoum, R.; Vernoux, P.; Pierson, J. Chemistry, phase formation, and catalytic activity of thin palladium-containing oxide films synthesized by plasma-assisted physical vapor deposition. Surf. Coat. Technol. 2011, 205, S171–S177. [Google Scholar] [CrossRef]
- Alsammarraie, K.; Wang, W.; Zhou, P.; Mustapha, A.; Lin, M. Green synthesis of silver nanoparticles using turmeric extracts and investigation of their antibacterial activities. Colloids Surf B Biointerfaces 2018, 171, 398–405. [Google Scholar] [CrossRef]
- Ying, S.; Guan, Z.; Ofoegbu, P.C.; Clubb, P.; Rico, C.; He, F.; Hong, J. Green Synthesis of Nanoparticles: Current Developments and Limitations. Environ. Technol. Innov. 2022, 26, 102336. [Google Scholar] [CrossRef]
- Bedlovičová, Z. Chapter 21—Green synthesis of silver nanoparticles using actinomycetes. In Green Synthesis of Silver Nanomaterials; A volume in Nanobiotechnology for Plant Protection; Abd-Elsalam, K.A., Ed.; Elsevier: Amsterdam, The Netherlands, 2022; pp. 547–569. [Google Scholar]
- Castillo-Henríquez, L.; Alfaro-Aguilar, K.; Ugalde-Álvarez, J.; Vega-Fernández, L.; Montes de Oca-Vásquez, G.; Vega-Baudrit, J.R. Green Synthesis of Gold and Silver Nanoparticles from Plant Extracts and Their Possible Applications as Antimicrobial Agents in the Agricultural Area. Nanomaterials 2020, 10, 1763. [Google Scholar] [CrossRef] [PubMed]
- Rónavári, A.; Igaz, N.; Adamecz, D.I.; Szerencsés, B.; Molnar, C.; Kónya, Z.; Pfeiffer, I.; Kiricsi, M. Green Silver and Gold Nanoparticles: Biological Synthesis Approaches and Potentials for Biomedical Applications. Molecules 2021, 26, 844. [Google Scholar] [CrossRef]
- Lubis, F.A.; Malek, N.A.; Sani, N.S.; Jemon, K. Biogenic Synthesis of Silver Nanoparticles Using Persicaria odorata Leaf Extract: Antibacterial, Cytocompatibility, and In Vitro Wound Healing Evaluation. Particuology 2022, 70, 10–19. [Google Scholar] [CrossRef]
- Batool, Z.; Muhammad, G.; Iqbal, M.M.; Aslam, S.M.; Raza, A.M.; Sajjad, N.; Abdullah, M.; Akhtar, N.; Syed, A.; Elgorban, A.M.; et al. Hydrogel assisted synthesis of gold nanoparticles with enhanced microbicidal and in vivo wound healing potential. Sci. Rep. 2022, 12, 6575. [Google Scholar] [PubMed]
- Chitra, S.; Mathew, N.K.; Jayalakshmi, S.; Balakumar, S.; Rajeshkumar, S.; Ramya, R. Strategies of Bioceramics, Bioactive Glasses in Endodontics: Future Perspectives of Restorative Dentistry. Biomed. Res. Int. 2022, 2022, 2530156. [Google Scholar] [CrossRef] [PubMed]
- Zhang, H.; Ma, W.; Ma, H.; Qin, C.; Chen, J.; Wu, C. Spindle-Like Zinc Silicate Nanoparticles Accelerating Innervated and Vascularized Skin Burn Wound Healing. Adv. Healthc. Mater. 2022, 11, e2102359. [Google Scholar] [CrossRef] [PubMed]
- Anandhi, P.; Rajeshkumar, S. Copper nanoparticles in wound healing: A review. J. Surv. Fish. Sci. 2023, 10, 49–63. [Google Scholar]
- Alhalili, Z. Green synthesis of copper oxide nanoparticles CuO NPs from Eucalyptus Globoulus leaf extract Adsorption and design of experiments. Arab. J. Chem. 2022, 15, 103739. [Google Scholar] [CrossRef]
- Alahdal, F.A.M.; Qashqoosh, M.T.A.; Manea, Y.K.; Mohammed, R.K.A.; Naqvi, S. Green synthesis and characterization of copper nanoparticles using Phragmanthera austroarabica extract and their biological/environmental applications. Sustain. Mater. Technol. 2023, 35, e00540. [Google Scholar] [CrossRef]
- Rizzi, V.; Gubitosa, J.; Fini, P.; Nuzzo, S.; Agostiano, A.; Cosma, P. Snail Slime-Based Gold Nanoparticles: An Interesting Potential Ingredient in Cosmetics as an Antioxidant, Sunscreen, and Tyrosinase Inhibitor. Photochem. Photobiol. B 2021, 224, 112309. [Google Scholar] [CrossRef] [PubMed]
- Gubitosa, J.; Rizzi, V.; Fini, P.; Laurenzana, A.; Fibbi, G.; Veiga-Villauriz, C.; Fanelli, F.; Fracassi, F.; Onzo, A.; Bianco, G.; et al. Biomolecules from Snail Mucus (Helix Aspersa) Conjugated Gold Nanoparticles, Exhibiting Potential Wound Healing and Anti-Inflammatory Activity. Soft Matter 2020, 16, 10876–10888. [Google Scholar] [CrossRef] [PubMed]
- Noothuan, N.; Apitanyasai, K.; Panha, S.; Tassanakajon, A. Snail Mucus from the Mantle and Foot of Two Land Snails, Lissachatina fulica and Hemiplecta distincta, Exhibits Different Protein Profile and Biological Activity. BMC Res. Notes 2021, 14, 138. [Google Scholar] [CrossRef] [PubMed]
- Ajaykumar, P.; Sabira, O.; Sebastian, M. A novel approach for the biosynthesis of silver nanoparticles using the defensive gland extracts of the beetle, Luprops tristis Fabricius. Sci. Rep. 2023, 13, 10186. [Google Scholar] [CrossRef] [PubMed]
- Mane, P.C.; Sayyed, S.A.R.; Kadam, D.D.; D Shinde, M.; Fatehmulla, A.; Aldhafiri, A.M.; Alghamdi, E.A.; Amalnerkar, D.P.; Chaudhari, R.D. Terrestrial snail-mucus mediated green synthesis of silver nanoparticles and in vitro investigations on their antimicrobial and anticancer activities. Sci. Rep. 2021, 11, 13068–13083. [Google Scholar] [CrossRef] [PubMed]
- Mane, C.; Kadam, D.; Khadse, N. Green Adeptness in Synthesis of Non-Toxic Copper and Cobalt Oxide Nanocomposites with Multifaceted Bioactivities. Cancer Nano 2023, 14, 79. [Google Scholar] [CrossRef]
- Wargala, E.; Zalewska, A.; Sławska, M.; Kot, I. Snail Mucus as an Innovative Ingredient Used in the Cosmetology and Medical Industry. Aesth. Cosmetol. Med. 2023, 12, 45–49. [Google Scholar] [CrossRef]
- Aouji, M.; Rkhaila, A.; Bouhaddioui, B.; Khalid, G.; Lrhorfi, L.A.; Bengueddour, R. Antioxidant activity, biochemical composition and physicochemical properties of Helix aspersa Muller snail slime. Molecules 2023, 28, 6323. [Google Scholar] [CrossRef] [PubMed]
- Aouji, M.; Rkhaila, A.; Bouhaddioui, B.; Ziraric, M.; Harifid, H.; Taboza, Y.; Lrhorfia, A.L.; Bengueddour, R. Chemical composition, mineral profile, anti-bacterial and wound healing properties of snail slime of Helix aspersa Müller. BioMedicine 2023, 13, 4. [Google Scholar] [CrossRef] [PubMed]
- Dolashki, A.; Velkova, L.; Daskalova, E.; Zheleva, N.; Topalova, Y.; Atanasov, V.; Voelter, W.; Dolashka, P. Antimicrobial Activities of Different Fractions from Mucus of the Garden Snail Cornu aspersum. Biomedicines 2020, 8, 315. [Google Scholar] [CrossRef] [PubMed]
- Belouhova, M.; Daskalova, E.; Yotinov, I.; Topalova, Y.; Velkova, L.; Dolashki, A.; Dolashka, P. Microbial diversity of garden snail mucus. Microbiologyopen 2020, 11, e1263. [Google Scholar] [CrossRef] [PubMed]
- Trapella, C.; Rizzo, R.; Gallo, S.; Alogna, A.; Bortolotti, D.; Casciano, F.; Zauli, G.; Secchiero, P.; Voltan, R. HelixComplex snail mucus exhibits pro-survival, proliferative and pro-migration effects on mammalian fibroblasts. Sci. Rep. 2018, 8, 17665. [Google Scholar] [CrossRef] [PubMed]
- Gentili, V.; Bortolotti, D.; Benedusi, M.; Alogna, A.; Fantinati, A.; Guiotto, A.; Turrin, G.; Cervellati, C.; Trapella, C.; Rizzo, R.; et al. HelixComplex snail mucus as a potential technology against O3 induced skin damage. PLoS ONE 2020, 15, e0229613. [Google Scholar] [CrossRef] [PubMed]
- Deng, T.; Gao, D.; Song, X.; Zhou, Z.; Zhou, L.; Tao, M.; Jiang, Z.; Yang, L.; Luo, L.; Zhou, A.; et al. A natural biological adhesive from snail mucus for wound repair. Nat. Commun. 2023, 14, 396. [Google Scholar] [CrossRef] [PubMed]
- Di Filippo, M.F.; Di Matteo, V.; Dolci, L.S.; Albertini, B.; Ballarin, B.; Cassani, M.C.; Passerini, N.; Gentilomi, G.A.; Bonvicini, F.; Panzavolta, S. Effectiveness of Snail Slime in the Green Synthesis of Silver Nanoparticles. Nanomaterials 2022, 12, 3447. [Google Scholar] [CrossRef] [PubMed]
- Woźniak-Budych, M.J.; Staszak, K.; Staszak, M. Copper and Copper-Based Nanoparticles in Medicine-Perspectives and Challenges. Molecules 2023, 28, 6687. [Google Scholar] [CrossRef] [PubMed]
- Dolashka, P.; Atanasov, D. Device for Collecting Extracts from Garden Snail. BG Useful model 2097. 2015. Available online: https://portal.bpo.bg/bpo_online/-/bpo/utility-model-detail (accessed on 6 April 2024).
- Berger, J. Infrared and Raman spectra of CuSO4, 5H2O; CuSO4, 5D2O; and CuSeO4, 5H2O. J. Raman Spectrosc. 1976, 5, 103–114. [Google Scholar] [CrossRef]
- Márquez, A.; Berger, T.; Feinle, A.; Hüsing, N.; Himly, M.; Duschl, A.; Diwald, O. Bovine Serum Albumin Adsorption on TiO2 Colloids: The Effect of Particle Agglomeration and Surface Composition. Langmuir 2017, 33, 2251–2258. [Google Scholar] [CrossRef] [PubMed]
- Umar, A.; Alshahrani, A.; Algarni, H.; Kumar, R. CuO Nanosheets as Potential Scaffolds for Gas Sensing Applications. Sens. Actuators B Chem. 2017, 250, 24–31. [Google Scholar] [CrossRef]
- Saied, E.; Hussein, A.; Al-Askar, A.; Elhussieny, N.; Hashem, A. Therapeutic Effect of Biosynthesized Silver Nanoparticles on Hypothyroidism Induced in Albino Rats. Electron. Biotechnol 2023, 65, 14–23. [Google Scholar]
- Tahir, B.; Sohaib, M.; Sagir, M.; Rafique, M. Role of Nanotechnology in Photocatalysis. Encycl. Smart Mater. 2022, 2, 578–589. [Google Scholar]
- Ellijimi, C.; Hammouda, B.; Othman, H. Helix aspersa maxima mucus exhibits antimelanogenic and antitumoral effects against melanoma cells. Biomed. Pharmacother. 2018, 101, 871–880. [Google Scholar] [CrossRef] [PubMed]
- Ekin, İ.; Şeşen, R. Molluscs: Their Usage as Nutrition, Medicine, Aphrodisiac, Cosmetic, Jewelry, Cowry, Pearl, Accessory and So on from the History to Today. Middle East J. Sci. 2018, 4, 45–51. [Google Scholar] [CrossRef]
- Giovanni, C.; Filippo, F. Antimicrobial properties of terrestrial snail and slug mucus. J. Complement. Integr. Med. 2018, 15, 20170168. [Google Scholar]
- Xie, J.; Lee, J.Y.; Wang, D.I.C.; Ting, Y.P. Silver Nanoplates: From Biological to Biomimetic Synthesis. ACS Nano 2007, 1, 429–439. [Google Scholar] [CrossRef]
- Uthayakumar, V.; Ramasubramanian, V.; Senthilkumar, D.; Priyadarisini, V.B.; Harikrishanan, R. Biochemical characterization, antimicrobial and hemolytic studies on skin mucus of freshwater spiny eel Mastacembelus armatus. Asian Pac. J. Trop. Biomed. 2012, 2, s863–s869. [Google Scholar] [CrossRef]
- Gabriel, U.I.; Mirela, S.; Ionel, J. Quantification of mucoproteins (glycoproteins) from snails mucus, Helix aspersa and Helix pomatia. J. Agroaliment. Process. Technol. 2011, 17, 410–413. [Google Scholar]
- Drozd, M.; Duszczyk, A.; Ivanova, P.; Pietrzak, M. Interactions of proteins with metal-based nanoparticles from a point of view of analytical chemistry—Challenges and opportunities. Adv. Colloid Interface Sci. 2022, 304, 102656. [Google Scholar] [CrossRef] [PubMed]
- Wang, S.; Zheng, J.; Ma, L.; Petersen, R.B.; Xu, L.; Huang, K. Inhibiting protein aggregation with nanomaterials: The underlying mechanisms and impact factors. Biochim. Biophys. Acta-Gen. Subj. 2022, 1866, 130061. [Google Scholar] [CrossRef] [PubMed]
- John, R.; Mathew, J.; Mathew, A.; Aravindakumar, C.T.; Aravind, U.K. Probing the Role of Cu(II) Ions on Protein Aggregation Using Two Model Proteins. ACS Omega 2021, 6, 35559–35571. [Google Scholar] [CrossRef]
- Royer, C.A. Probing protein folding and conformational transitions with fluorescence. Chem. Rev. 2006, 106, 1769–1784. [Google Scholar] [CrossRef] [PubMed]
- Saravanan, A.; Kumar, S.; Karishma, S.; Vo, D.N.; Jeevanantham, S.; Yaashikaa, P.R.; George, C.S. A Review on Biosynthesis of Metal Nanoparticles and Its Environmental Applications. Chemosphere 2021, 264 Pt 2, 128580. [Google Scholar] [CrossRef]
- Rashad, M.; Sampò, S.; Cataldi, A.; Zara, S. Biological activities of gastropods secretions: Snail and slug slime. Nat. Prod. Bioprospect. 2023, 13, 42. [Google Scholar] [CrossRef] [PubMed]
- Ortelli, R.; Costa, A.L.; Blosi, M.; Brunelli, A.; Badetti, E.; Bonetto, A.; Hristozov, D.; Marcomini, A. Colloidal characterization of CuO nanoparticles in biological and environmental media. Environ. Sci. Nano 2017, 4, 1264–1272. [Google Scholar] [CrossRef]
- Baldisserri, C.; Costa, A.L. Electrochemical detection of copper ions leached from CuO nanoparticles in saline buffers and biological media using a gold wire working electrode. Nanopart. Res. 2016, 18, 96. [Google Scholar] [CrossRef]
- Chrzanowska, A.; Derylo-Marczewska, A. Mesoporous silica/protein biocomposites: Surface, topography, thermal properties. Int. J. Biol. Macromol. 2019, 139, 531–542. [Google Scholar] [CrossRef] [PubMed]
- Andrade, J.D.; Hlady, V.; Wei, A.P. Adsorption of complex proteins at interfaces. Pure Appl. Chem. 1992, 64, 1777–1781. [Google Scholar] [CrossRef]
- Dee, K.C.; Puleo, D.A.; Bizios, R. Chapter 3—Protein-surface interactions. In An Introduction to Tissue-Biomaterial Interactions; John Wiley & Sons, Inc.: Hoboken, NJ, USA, 2002; pp. 37–52. [Google Scholar]
- Brieva, A.; Philips, N.; Tejedor, R.; Guerrero, A.; Pivel, J.P.; Alonso-Lebrero, J.L.; Gonzalez, S. Molecular basis for the regenerative properties of a secretion of the mollusk Cryptomphalus aspersa. Ski. Pharmacol. Physiol. 2008, 21, 15–22. [Google Scholar] [CrossRef] [PubMed]
- Kostadinova, N.; Voynikov, Y.; Dolashki, A.; Krumova, E.; Abrashev, R.; Kowalewski, D.; Stevanovic, S.; Velkova, L.; Velikova, R.; Dolashka, P. Antioxidative screening of fractions from the mucus of garden snail Cornu aspersum. Bul. Chem. Com. 2018, 50, 176–183. [Google Scholar]
- Tancheva, L.; Lazarova, M.; Velkova, L.; Dolashki, A.; Uzunova, D.; Minchev, B.; Petkova-Kirova, P.; Hassanova, Y.; Gavrilova, P.; Tasheva, K.; et al. Beneficial effects of snail Helix aspersa extract in an experimental model of Alzheimer’s type dementia. J. Alzheimers Dis. 2022, 88, 155–175. [Google Scholar] [PubMed]
- Petrov, L.; Kachaunov, M.; Alexandrova, A.; Tsvetanova, E.; Georgieva, A.; Dolashki, A.; Velkova, L.; Dolashka, P. Snail Mucus Protective Effect on Ethanol-Induced Gastric Ulcers in Mice. Life 2022, 12, 1106. [Google Scholar] [CrossRef] [PubMed]
- Pitt, S.; Hawthorne, J.A.; Garcia-Maya, M.; Alexandrovich, A.; Symonds, R.C.; Gunn, A. Identification and characterisation of anti—Pseudomonas aeruginosa proteins in mucus of the brown garden snail, Cornu aspersum. Br. J. Biomed. Sci. 2019, 76, 129–136. [Google Scholar] [CrossRef] [PubMed]
- Tahir, A.; Quispe, C.; Herrera-Bravo, J.; Iqbal, H.; ul Haq, Z.; Anum, F.; Javed, Z.; Sehar, A. Green Synthesis, Characterization and Antibacterial, Antifungal, Larvicidal and Anti-Termite Activities of Copper Nanoparticles Derived from Grewia asiatica L. Bull. Natl. Res. Cent. 2022, 46, 188. [Google Scholar] [CrossRef]
- Das, K.R.; Pachapur, V.L.; Lonappan, L.; Naghdi, M.; Pulicharla, R.; Maiti, S.; Cledon, M.; Dalila, L.M.A.; Srama, S.J.; Brar, S.K. Biological synthesis of metallic nanoparticles: Plants, animals and microbial aspects. Nanotechnol. Environ. Eng. 2017, 2, 18. [Google Scholar] [CrossRef]
- Antonio-Pérez, A.; Durán-Armenta, L.F.; Pérez-Loredo, M.G.; Torres-Huerta, A.L. Biosynthesis of Copper Nanoparticles with Medicinal Plants Extracts: From Extraction Methods to Applications. Micromachines 2023, 14, 1882. [Google Scholar] [CrossRef] [PubMed]
- Akintelu, S.A.; Folorunso, A.S.; Folorunso, F.A.; Oyebamiji, A.K. Green synthesis of copper oxide nanoparticles for biomedical application and environmental remediation. Heliyon 2020, 6, e04508. [Google Scholar] [CrossRef] [PubMed]
- Luque-Jacobo, C.M.; Cespedes-Loayza, A.L.; Echegaray-Ugarte, T.S.; Cruz-Loayza, J.L.; Cruz, I.; de Carvalho, J.C.; Goyzueta-Mamani, L.D. Biogenic Synthesis of Copper Nanoparticles: A Systematic Review of Their Features and Main Applications. Molecules 2023, 28, 4838. [Google Scholar] [CrossRef] [PubMed]
- Gu, J.; Aidy, A.; Goorani, S. Anti-Human Lung Adenocarcinoma, Cytotoxicity, and Antioxidant Potentials of Copper Nanoparticles Green-Synthesized by Calendula Officinalis. J. Exp. Nanosci. 2022, 17, 285–296. [Google Scholar] [CrossRef]
- Siddiqui, M.A.; Alhadlaq, H.A.; Ahmad, J.; Al-Khedhairy, A.A.; Musarrat, J.; Ahamed, M. Copper Oxide Nanoparticles Induced Mitochondria Mediated Apoptosis in Human Hepatocarcinoma Cells. PLoS ONE 2013, 8, e69534. [Google Scholar] [CrossRef]
- Valeria, C.; Salvatore, P.; Luca, V.; Maria, G.; Ludovica, M.; Cristina, S.; Lucia, M.; Angela, C.; Valeria, S. Innovative snail-mucus-extract (SME)-coated nanoparticles exhibit anti-inflammatory and anti-proliferative effects for potential skin cancer prevention and treatment. RSC Adv. 2024, 14, 7655–7663. [Google Scholar] [CrossRef] [PubMed]
- Rosli, N.A.; Teow, Y.H.; Mahmoudi, E. Current approaches for the exploration of antimicrobial activities of nanoparticles. Sci. Technol. Adv. Mater. 2021, 22, 885–907. [Google Scholar] [CrossRef] [PubMed]
- Wang, L.; Hu, C.; Shao, L. The antimicrobial activity of nanoparticles: Present situation and prospects for the future. Int. J. Nanomed. 2017, 12, 1227–1249. [Google Scholar] [CrossRef] [PubMed]
- Sarwar, A.; Katas, H.; Samsudin, S.N.; Zin, N.M. Regioselective sequential modification of chitosan via azide-alkyne click reaction: Synthesis, characterization, and antimicrobial activity of chitosan derivatives and nanoparticles. PLoS ONE 2015, 10, e0123084. [Google Scholar] [CrossRef] [PubMed]
- Mancuso, G.; Midiri, A.; Gerace, E.; Biondo, C. Bacterial Antibiotic Resistance: The Most Critical Pathogens. Pathogens 2021, 10, 1310–1323. [Google Scholar] [CrossRef]
- Singh, P.; Garg, A.; Pandit, S.; Mokkapati, V.R.S.S.; Mijakovic, I. Antimicrobial effects of biogenic nanoparticles. Nanomaterials 2018, 8, 1009. [Google Scholar] [CrossRef] [PubMed]
- Selim, S. Mechanisms of gram-positive vancomycin resistance (Review). Biomed. Rep. 2022, 16, 7–12. [Google Scholar] [CrossRef] [PubMed]
- Trifi, A.; Tlili, B.; Kallel Sellami, M.; Feki, M.; Mehdi, A.; Seghir, E.; Messaoud, L.; Abdellatif, S.; Ben Lakhal, S. Immunologic effect and clinical impact of erythromycin in septic patients: A randomized clinical trial. J. Crit. Care 2024, 81, 154533. [Google Scholar] [CrossRef] [PubMed]
- Bradford, M.M. A rapid and sensitive method for the quantitation of microgram quantities of protein utilizing the principle of protein-dye binding. Anal. Biochem. 1976, 72, 248–254. [Google Scholar] [CrossRef] [PubMed]
- Laemmli, U.K. Cleavage of structural proteins during the assembly of the head of bacteriophage T4. Nature 1970, 227, 680–685. [Google Scholar] [CrossRef] [PubMed]
- Xu, J.F.; Ji, W.; Shen, Z.X.; Li, W.S.; Tang, S.H.; Ye, X.R.; Xin, X.Q. Raman spectra of CuO nanocrystals. J. Raman Spectrosc. 1999, 30, 413–415. [Google Scholar] [CrossRef]
- Umer, A.; Naveed, S.; Rafique, M.S.; Imran, M. A green method for the synthesis of Copper Nanoparticles using L-ascorbic acid. Matéria (Rio J.) 2014, 19, 197–203. [Google Scholar] [CrossRef]
- Lincz, L.F.; Scorgie, F.E.; Garg, M.B.; Gilbert, J.; Sakoff, J.A. A simplified method to calculate telomere length from Southern blot images of terminal restriction fragment lengths. Biotechniques 2020, 68, 28–34. [Google Scholar] [CrossRef] [PubMed]
- Balouiri, M.; Sadiki, M.; Ibnsouda, S. Methods for in vitro evaluating antimicrobial activity: A review. J. Pharm. Anal. 2016, 6, 71–79. [Google Scholar] [CrossRef] [PubMed]
- Clinical and Laboratory Standards Institute. Analysis and Presentation of Cumulative Antimicrobial Susceptibility Test Data, 5th ed.; Approved guideline; Clinical and Laboratory Standards Institute: Wayne, PA, USA, 2022. [Google Scholar]

| Wavenumber [cm−1] | Interaction |
|---|---|
| 616 | Cu–O |
| 1102 | C–O bending |
| 1414 | C–N stretching |
| 1530 | NH |
| 1641 | O–H bending |
| 2978 | C–H stretching |
| 3251 | O–H stretching |
| Sample | TG | DTG | |||||
|---|---|---|---|---|---|---|---|
| Mloss,IDS [%] | Mloss1 [%] | Mloss2 [%] | Mloss,TOTAL [%] | Tmax,IDS [°C] | Tmax1 [°C] | Tmax2 [°C] | |
| 30–120 [°C] | 120–200 [°C] | 200–300 [°C] | |||||
| Mucus | 16.94% (9.08 mg) | 75.75% (40.64 mg) | 0.03% (0.016 mg) | 92.72% | 73.3 | 123.0 | 183.0 |
| CuONPs | 23.47% (11.49 mg) | 69.44% (34.05 mg) | 0.04% (0.019 mg) | 92.95% | 62.2 | 134.9 | 160.9 |
| Sample | DSC | |||||||
|---|---|---|---|---|---|---|---|---|
| Tonset [°C] | Tpeak [°C] | Tend [°C] | ∆H J/g | Tonset [°C] | Tpeak [°C] | Tend [°C] | ∆H J/g | |
| Mucus | 58.2 | 80.8 | 91.1 | −289.2 | 127.9 | 183.9 | 189.0 | −1216 |
| CuONPs | 35.3 | 65.2 | 85.4 | −183.8 | 125.3 | 158.9 | 181.7 | −1058 |
Disclaimer/Publisher’s Note: The statements, opinions and data contained in all publications are solely those of the individual author(s) and contributor(s) and not of MDPI and/or the editor(s). MDPI and/or the editor(s) disclaim responsibility for any injury to people or property resulting from any ideas, methods, instructions or products referred to in the content. |
© 2024 by the authors. Licensee MDPI, Basel, Switzerland. This article is an open access article distributed under the terms and conditions of the Creative Commons Attribution (CC BY) license (https://creativecommons.org/licenses/by/4.0/).
Share and Cite
Dolashka, P.; Marinova, K.; Petrov, P.; Petrova, V.; Ranguelov, B.; Atanasova-Vladimirova, S.; Kaynarov, D.; Stoycheva, I.; Pisareva, E.; Tomova, A.; et al. Development of CuO Nanoparticles from the Mucus of Garden Snail Cornu aspersum as New Antimicrobial Agents. Pharmaceuticals 2024, 17, 506. https://doi.org/10.3390/ph17040506
Dolashka P, Marinova K, Petrov P, Petrova V, Ranguelov B, Atanasova-Vladimirova S, Kaynarov D, Stoycheva I, Pisareva E, Tomova A, et al. Development of CuO Nanoparticles from the Mucus of Garden Snail Cornu aspersum as New Antimicrobial Agents. Pharmaceuticals. 2024; 17(4):506. https://doi.org/10.3390/ph17040506
Chicago/Turabian StyleDolashka, Pavlina, Karina Marinova, Petar Petrov, Ventsislava Petrova, Bogdan Ranguelov, Stella Atanasova-Vladimirova, Dimitar Kaynarov, Ivanka Stoycheva, Emiliya Pisareva, Anna Tomova, and et al. 2024. "Development of CuO Nanoparticles from the Mucus of Garden Snail Cornu aspersum as New Antimicrobial Agents" Pharmaceuticals 17, no. 4: 506. https://doi.org/10.3390/ph17040506
APA StyleDolashka, P., Marinova, K., Petrov, P., Petrova, V., Ranguelov, B., Atanasova-Vladimirova, S., Kaynarov, D., Stoycheva, I., Pisareva, E., Tomova, A., Kosateva, A., Velkova, L., & Dolashki, A. (2024). Development of CuO Nanoparticles from the Mucus of Garden Snail Cornu aspersum as New Antimicrobial Agents. Pharmaceuticals, 17(4), 506. https://doi.org/10.3390/ph17040506

